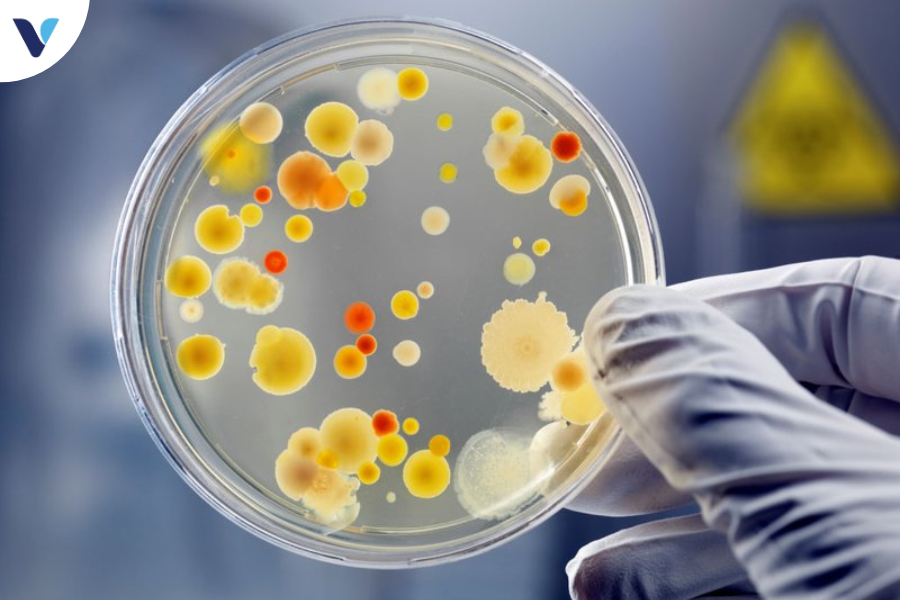

Bệnh lậu có khỏi hẳn được không?
Bệnh lậu là một trong những bệnh lây truyền qua đường tình dục phổ biến, gây lo lắng cho nhiều người về khả năng chữa khỏi và những hậu quả tiềm ẩn. Với triệu chứng không rõ ràng, bệnh lậu dễ dàng lây lan và gây ra nhiều biến chứng nguy hiểm nếu không được điều trị kịp thời. Vậy, liệu bệnh lậu có thể khỏi hẳn hay không? hay người bệnh phải sống chung với nó suốt đời?.

Bệnh lậu là gì?
Bệnh lậu là một trong những bệnh lây truyền qua đường tình dục (STD) phổ biến, do vi khuẩn Neisseria gonorrhoeae gây ra. Vi khuẩn này chủ yếu tấn công các khu vực ẩm ướt của cơ thể như cơ quan sinh dục, cổ họng và trực tràng. Bệnh có thể ảnh hưởng đến cả nam và nữ ở mọi lứa tuổi nhưng phổ biến nhất ở người trẻ từ 15 đến 24 tuổi. Vì lây nhiễm nhanh chóng qua tiếp xúc trực tiếp trong quan hệ tình dục, bệnh lậu là một vấn đề y tế đáng lo ngại.
Triệu chứng bệnh lậu
Triệu chứng bệnh lậu ở nam giới
Triệu chứng của bệnh lậu ở nam giới thường xuất hiện trong vòng 2 đến 14 ngày sau khi nhiễm khuẩn. Một số triệu chứng phổ biến bao gồm:
- Tiểu buốt, đau khi tiểu tiện: Đây là một trong những triệu chứng đầu tiên và thường gặp nhất. Nam giới có thể cảm thấy đau rát hoặc buốt mỗi khi đi tiểu, do niệu đạo bị nhiễm khuẩn và viêm nhiễm.
- Chảy mủ từ dương vật: Triệu chứng này thường xuất hiện sau vài ngày khi bệnh tiến triển. Dịch mủ có thể có màu trắng đục, vàng hoặc xanh. Lượng mủ có thể nhiều hoặc ít tùy thuộc vào mức độ nhiễm trùng.
- Đau hoặc sưng ở một hoặc cả hai tinh hoàn: Trong một số trường hợp, vi khuẩn có thể lan tới mào tinh hoàn, gây viêm mào tinh hoàn. Tình trạng này thường gây đau và sưng tinh hoàn, có thể dẫn đến biến chứng nghiêm trọng nếu không được điều trị.
- Ngứa và rát ở vùng niệu đạo: Triệu chứng này thường đi kèm với cảm giác đau khi tiểu và chảy mủ. Ngứa ở khu vực niệu đạo khiến người bệnh cảm thấy khó chịu và dễ bị kích ứng.
Triệu chứng bệnh lậu ở nữ giới
Triệu chứng bệnh lậu ở nữ giới thường nhẹ hơn và dễ bị nhầm lẫn với các bệnh nhiễm trùng khác, như viêm nhiễm âm đạo hoặc nhiễm trùng đường tiểu. Điều này làm cho việc chẩn đoán và điều trị bệnh lậu ở nữ giới phức tạp hơn. Các triệu chứng bao gồm:
- Dịch âm đạo bất thường: Nữ giới mắc bệnh lậu thường có dịch âm đạo nhiều hơn bình thường, dịch có thể có màu vàng hoặc xanh và mùi hôi.
- Đau khi tiểu tiện: Tương tự như nam giới, nữ giới cũng có cảm giác đau, rát khi tiểu tiện do niệu đạo bị nhiễm trùng.
- Đau vùng bụng dưới: Khi vi khuẩn lậu lan lên vùng tử cung hoặc ống dẫn trứng, phụ nữ có thể cảm thấy đau ở vùng bụng dưới, thường giống như đau trong kỳ kinh nguyệt nhưng kéo dài hơn.
- Đau khi quan hệ tình dục: Vi khuẩn gây nhiễm trùng các mô bên trong âm đạo, khiến cho quan hệ tình dục trở nên đau đớn. Đau khi quan hệ tình dục là một trong những dấu hiệu mà phụ nữ nên cảnh giác.
- Chảy máu bất thường ngoài kỳ kinh nguyệt: Phụ nữ mắc bệnh lậu có thể xuất hiện chảy máu nhẹ hoặc đốm máu giữa các chu kỳ kinh nguyệt, thường là do sự viêm nhiễm của niêm mạc tử cung.
Phương pháp điều trị bệnh lậu hiệu quả:
- Sử dụng kháng sinh: Phác đồ điều trị thông thường bao gồm một liều tiêm kháng sinh ceftriaxone và một liều uống azithromycin hoặc doxycycline. Phác đồ này đã được chứng minh là hiệu quả với phần lớn các trường hợp mắc bệnh lậu.
- Tái khám và theo dõi: Sau khi kết thúc liệu trình điều trị, người bệnh nên tái khám để xác định liệu bệnh đã hoàn toàn khỏi chưa. Việc này rất quan trọng vì vi khuẩn có thể vẫn tồn tại trong cơ thể ngay cả khi triệu chứng đã biến mất.
- Điều trị cho cả bạn tình: Để ngăn ngừa nguy cơ tái nhiễm, bạn tình của người bệnh cũng nên được điều trị, bất kể họ có triệu chứng hay không.
Bệnh lậu có thể chữa khỏi hẳn được không?
Câu hỏi “Bệnh lậu có khỏi hẳn được không?” là mối quan tâm chính của nhiều người. Câu trả lời là có, nếu được điều trị đúng cách và tuân thủ theo hướng dẫn của bác sĩ.
Điều trị bệnh lậu hiện nay chủ yếu dựa vào kháng sinh. Theo Trung tâm Kiểm soát và Phòng ngừa Dịch bệnh (CDC), các trường hợp bệnh lậu không biến chứng thường được điều trị hiệu quả bằng một liều tiêm kháng sinh duy nhất. Trong các trường hợp nghiêm trọng hơn hoặc bệnh lậu đã kháng thuốc, có thể cần một liệu trình dài hơn hoặc kết hợp nhiều loại kháng sinh.
Tuy nhiên, một điểm đáng lưu ý là các chủng vi khuẩn lậu đang dần phát triển khả năng kháng lại các loại kháng sinh thông dụng, khiến việc điều trị trở nên khó khăn hơn. Để tăng khả năng thành công trong việc điều trị, việc tuân thủ hoàn toàn liệu trình điều trị và tái khám sau khi hoàn tất là điều quan trọng.

Nếu bạn đã từng mắc bệnh lậu, hãy lưu ý các điều sau:
- Không tự ý ngừng điều trị trước khi hoàn tất liệu trình được bác sĩ chỉ định, vì điều này có thể dẫn đến kháng thuốc và làm giảm hiệu quả điều trị.
- Tái khám định kỳ để kiểm tra xem liệu bệnh đã thực sự khỏi hay chưa.
- Nói chuyện với bác sĩ nếu cảm thấy có bất kỳ triệu chứng nào tái phát sau khi đã hoàn tất liệu trình điều trị.
Trong một số trường hợp, bệnh lậu có thể để lại ảnh hưởng lâu dài nếu không được điều trị kịp thời. Điều này bao gồm vô sinh, đau kéo dài ở vùng sinh dục, và nguy cơ lây nhiễm HIV cao hơn. Tuy nhiên, với phương pháp điều trị hiện đại và ý thức phòng ngừa tốt, hầu hết các bệnh nhân có thể phục hồi hoàn toàn và không gặp phải biến chứng.

Nguy cơ tái nhiễm bệnh lậu
Mặc dù bệnh lậu có thể chữa khỏi hoàn toàn bằng kháng sinh, người đã từng bị nhiễm có thể dễ dàng bị tái nhiễm nếu tiếp tục có hành vi quan hệ tình dục không an toàn với người nhiễm bệnh. Điều này có nghĩa là:
-
Việc quan hệ tình dục an toàn và sử dụng bao cao su là cần thiết để ngăn ngừa tái nhiễm.
- Khám sức khỏe định kỳ, đặc biệt nếu có nhiều bạn tình hoặc đã từng nhiễm bệnh, cũng giúp phát hiện sớm và điều trị kịp thời.
Nếu không được điều trị kịp thời, bệnh lậu có thể dẫn đến nhiều biến chứng nghiêm trọng:
- Ở nữ giới: bệnh có thể gây viêm vùng chậu (PID), một tình trạng đau đớn và có thể dẫn đến vô sinh.
- Ở nam giới: bệnh có thể gây viêm mào tinh hoàn, đau và có khả năng gây vô sinh nếu không được chữa trị.
- Lây nhiễm sang các bộ phận khác: vi khuẩn có thể lan sang máu hoặc khớp, gây ra các tình trạng nguy hiểm như viêm màng não, viêm tim, hoặc nhiễm trùng toàn thân.
Phòng ngừa bệnh lậu như thế nào?
Phòng ngừa bệnh lậu là bước quan trọng để bảo vệ sức khỏe của bản thân và đối tác. Các biện pháp phòng ngừa hiệu quả bao gồm:
- Sử dụng bao cao su trong mỗi lần quan hệ tình dục, kể cả quan hệ miệng hoặc hậu môn.
- Khám sức khỏe định kỳ và thực hiện xét nghiệm bệnh lây truyền qua đường tình dục nếu có nguy cơ cao.
- Tránh quan hệ tình dục với nhiều bạn tình, đặc biệt nếu không biết rõ về tình trạng sức khỏe của họ.
- Tuyên truyền và nâng cao nhận thức về bệnh lậu cũng như các bệnh tình dục khác để hạn chế nguy cơ lây lan.



